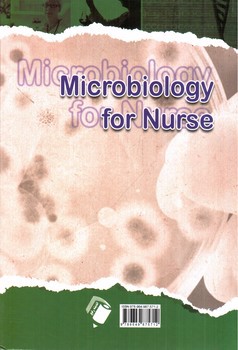
تصویر کتاب میکروب شناسی برای پرستار

میکروب شناسی برای پرستار
میکروب شناسی برای پرستار


فارسی
1400
شومیز
سفید
وزیری
4
2000
216
321
این محصول فاقد توضیحات کامل می باشد
1,096,500 ریال
15% 1,290,000
2787.jpg
2787.jpg,2787-1.jpg